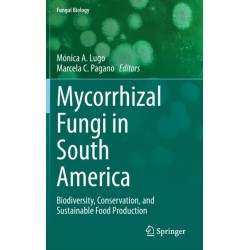
Mycorrhizal Fungi in South America: Biodiversity, Conservation, and Sustainable Food Production

Ingen varer
Udviklingsbiologi
Visning: Type : Alle | Sprog : Alle | Format : Alle
-
Bemærk: Kan ikke leveres før jul.
Assessing COVID-19 and Other Pandemics and Epidemics using Computational Modelling and Data Analysis (Bog, Paperback / softback, Engelsk)Levering: Skaffevare (forvent 14 - 30 hverdage) -
Bemærk: Kan ikke leveres før jul.
Cell Biology and Translational Medicine, Volume 14: Stem Cells in Lineage Specific Differentiation and Disease (Bog, Paperback / softback, Engelsk)Levering: Skaffevare (forvent 14 - 30 hverdage) -
Bemærk: Kan ikke leveres før jul.
Bone Marrow Niche: Microenvironments Critical for Immune Cell Development (Bog, Paperback / softback, Engelsk)Readers are introduced to the fundamentals of hematopoietic stem cells (HSCs) differentiation to all types of blood cells, including immune cells, in the bone marrow.
Levering: Skaffevare (forvent 14 - 30 hverdage) -
Bemærk: Kan ikke leveres før jul.
Mycorrhizal Fungi in South America: Biodiversity, Conservation, and Sustainable Food Production (Bog, Hardback, Engelsk)It includes new reports of mycorrhizal fungi diversity along different mycorrhizal types and their effect on... Læs mere
Levering: Skaffevare (forvent 14 - 30 hverdage) -
Bemærk: Kan ikke leveres før jul.
Epigenetics, Development, Ecology and Evolution (Bog, Hardback, Engelsk)Epigenetic modifications comprise heritable gene expression changes that occur without alteration of the DNA sequence and 'co-act' with genetic factors to shape development processes and evolutionary trajectories.
Levering: Skaffevare (forvent 14 - 30 hverdage) -
Bemærk: Kan ikke leveres før jul.
Autophagy in Stem Cell Maintenance and Differentiation (Bog, Hardback, Engelsk)This book covers a wide range of topics that illustrate the various functions of autophagy in stem cells and offers insights on the mechanisms by which autophagy can regulate stem-cell self-renewal and facilitate specific differentiation programs.
Levering: Skaffevare (forvent 14 - 30 hverdage) -
Bemærk: Kan ikke leveres før jul.
Matrix Pathobiology and Angiogenesis (Bog, Hardback, Engelsk)Levering: Skaffevare (forvent 14 - 30 hverdage) -
Bemærk: Kan ikke leveres før jul.
Stem cells: From Potential to Promise (Bog, Paperback / softback, Engelsk)Levering: Skaffevare (forvent 14 - 30 hverdage) -
Bemærk: Kan ikke leveres før jul.
Recent Advancement in White Biotechnology Through Fungi: Volume 2: Perspective for Value-Added Products and Environments (Bog, Hardback, Engelsk)White biotechnology is industrial biotechnology dealing with various biotech... Læs mere
Levering: Skaffevare (forvent 14 - 30 hverdage) -
Bemærk: Kan ikke leveres før jul.
Recent Advancement in White Biotechnology Through Fungi: Volume 3: Perspective for Sustainable Environments (Bog, Hardback, Engelsk)This discovery was a milestone in the development of white biotechnology as the industrial production of penicillin and antibiotics using fungi moved industrial biotechnology into the modern era, transforming it into a global industrial technology.
Levering: Skaffevare (forvent 14 - 30 hverdage) -
Bemærk: Kan ikke leveres før jul.
The Cytoskeleton: Diverse Roles in a Plant’s Life (Bog, Hardback, Engelsk)This book focuses on the plant cytoskeleton and its various cross-talks with other cellular components leading to its role in plant growth and development.
Levering: Skaffevare (forvent 14 - 30 hverdage) -
Bemærk: Kan ikke leveres før jul.
Natural Bio-active Compounds: Volume 1: Production and Applications (Bog, Paperback / softback, Engelsk)Bioactive compounds produced by natural sources, such as plants, microbes, endophytic fungi, etc., can potentially be applied in various fields, including agriculture, biotechnology and biomedicine.
Levering: Skaffevare (forvent 14 - 30 hverdage)